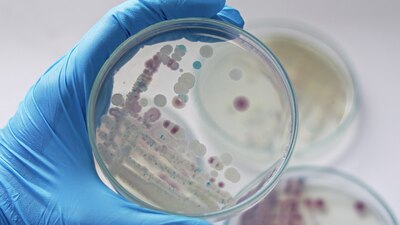

Los Centros para el Control y la Prevención de Enfermedades (CDC, por su siglas en inglés) alertaron de la presencia de la mortífera bacteria Vibrio vulnificus, conocida como la “devoradora de carne”, en aguas a lo largo de la costa este de Estados Unidos y el Golfo de México.
Al menos cinco personas han muerto durante este año en casos relacionados con la bacteria, según el Departamento de Salud de Florida.
Los Centros para el Control y la Prevención de Enfermedades alertaron este fin de semana a las instituciones sanitarias que la presencia de la bacteria se ha extendido en Estados Unidos y prospera en las aguas más cálidas del verano (mayo a octubre) y en ambientes marinos con bajo contenido de sal, como los estuarios.
La agencia federal advirtió de que anualmente unas 80 mil personas enferman a causa de esta bacteria, la mayoría de las veces cuando una persona ingiere mariscos contaminados. La bacteria también puede causar una infección al entrar por alguna herida abierta.
Según los CDC, cada año se notifican entre 150 y 200 infecciones por Vibrio vulnificus y aproximadamente una de cada cinco personas con esta infección muere, a veces entre uno y dos días después de enfermarse.
¿Dónde y quiénes son los más vulnerables por la bacteria ‘devoradora de carne’?
La Vibrio vulnificus es una bacteria que se encuentra en el agua de mar cálida y salobre que puede ingresar al torrente sanguíneo a través de cortes y rasguños recientes. Las infecciones causadas por la Vibrio vulnificus son raras y más graves que la mayoría de las demás.
La Vibrio vulnificus afecta especialmente a ancianos o personas mayores con problemas en su sistema inmunológico y solo se combate con antibióticos.
Los médicos aconsejan abstenerse de comer marisco crudo, especialmente ostras, y no bañarse en el mar o agua salobre con heridas o cortes recientes en la piel para evitar toda posibilidad de contagio.